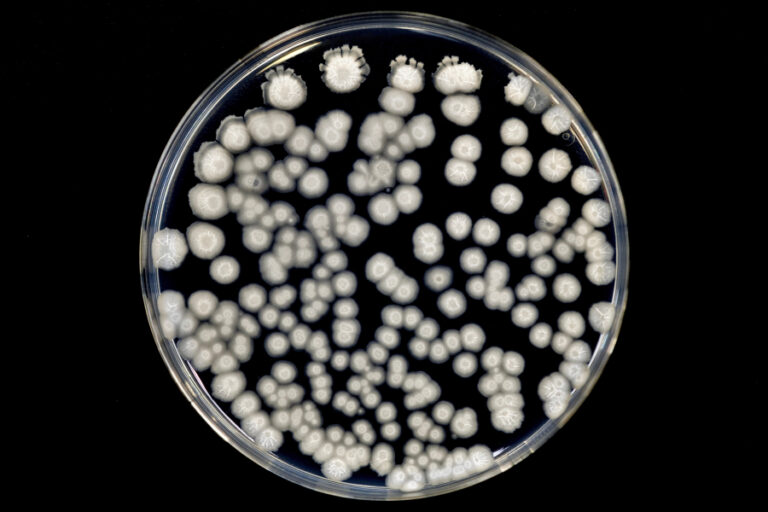
Aplicación Tamaño de partículas Banner - Paralab distribuye equipo de particle size en España.

SmartLab®
SmartLab es un sistema de difracción de rayos X de alta resolución totalmente automatizado con montaje y geometría de muestra horizontal θ/θ.

El tamaño de partículas es un parámetro clave en polvos, suspensiones, emulsiones y materiales nanoestructurados. Un buen particle size analysis permite entender cómo se relacionan particle size vs surface area, fluidez, reactividad, estabilidad de suspensiones o capacidad de compactación.
La particle size distribution –o distribución del tamaño de partículas– es tan importante como el valor medio: pequeñas variaciones en las fracciones finas o gruesas pueden cambiar por completo el rendimiento de un producto o proceso, desde la disolución de un comprimido hasta la reactividad de un catalizador.
Na aplicação tamaño de partículas, entram diferentes particle size measurement techniques adaptadas ao tipo de material. A medición del tamaño de partículas por SEM combina SEM particle size measurement con SEM para análisis de partículas y particle imaging para obtener imágenes de partículas de alta resolución. A partir delas se realiza SEM particle morphology analysis y análisis morfológico de partículas por SEM, avaliando morfología de partículas, forma, rugosidad e análisis de forma de partículas.
Para sólidos cristalinos, o XRD particle size analysis e o análisis de partículas por XRD utilizam o alargamento de picos de difração para estimar tamanho de cristalito. Com XRD for particle size determination e instrumentos de difracción para tamaño de partículas, é possível combinar particle size determination com caracterización estructural de partículas, ligando tamanho, fase cristalina e grau de ordem numa mesma medida.
A determinación del tamaño de partículas não se resume a um número médio. A aplicação também aborda medición de nanopartículas (nanoparticle size measurement), dispersão vs. aglomeração e estudio de aglomeración de partículas, distinguindo partícula primária de agregados ou aglomerados. Estes aspetos são críticos na particle characterization de pigmentos, catalizadores, cargas funcionais e princípios ativos farmacêuticos.
Em sistemas mais complexos, a NMR particle characterization e a caracterización de partículas por RMN oferecem informação complementar sobre mobilidade interna, distribuição de fases ou conteúdo de líquido em poros, funcionando como resonancia magnética para análisis de partículas que amplia aquilo que se observa por SEM e XRD.
Os equipos para análisis de tamaño de partículas modernos integram ótica, eletrónica e software para análisis automático de partículas e medida automática de partículas com alta repetibilidade. Um particle size analysis instrument pode combinar particle imaging, estatística avançada e ligação direta a sistemas de qualidade, facilitando a rastreabilidade.
Na oferta da Paralab, soluções de SEM para análisis de partículas, XRD particle size determination equipment e plataformas dedicadas tipo Particlemetric compõem um conjunto completo para particle structure characterization e particle size analysis em setores como mineração, química fina, farmacêutica, materiais de construção, energia e investigação académica.

SmartLab es un sistema de difracción de rayos X de alta resolución totalmente automatizado con montaje y geometría de muestra horizontal θ/θ.

El software Smartlab Studio Guidance hace que el control del difractómetro SmartLab SE sea accesible a todos los usuarios gracias a su

El microscopio electrónico de barrido de sobremesa (SEM) Thermo Scientific Phenom XL G2 de última generación automatiza su proceso de control de

El SEM para mostrador es fácil de usar desde la instalación inicial hasta el uso efectivo, teniendo en cuenta su diseño intuitivo

El microscopio electrónico de barrido Phenom Pure (SEM) es una herramienta ideal para la transición de la microscopía óptica a la electrónica.